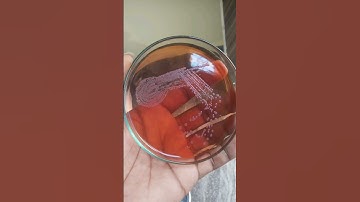
Bacterial colonies | culture media | bacterial growth on agar plates | how to grow bacteria #biology

⬇ DOWNLOAD NOW
Kalau muncul iklan pop-up, tutup lalu klik tombol kembali
Download lagu Kinetic Visualization of Interspecies Bacterial Interactions | Protocol Preview secara gratis hanya untuk keperluan promosi. Dukung artis favorit kamu dengan membeli musik original di iTunes atau platform resmi lainnya.
 Growth of Bacteria: Bacillus subtilis
Growth of Bacteria: Bacillus subtilis
 Bacteriophage 3D Animation|| Structure of Bacteriophage|| How Bacteriophage infect Bacteria?
Bacteriophage 3D Animation|| Structure of Bacteriophage|| How Bacteriophage infect Bacteria?
 Bacteria 3D Animation
Bacteria 3D Animation
 Agar plate streaking
Agar plate streaking
 Bacterial growth | Culture media | UTI |Bacteriology | Microorganisms |#bacteria #microbiology #lab
Bacterial growth | Culture media | UTI |Bacteriology | Microorganisms |#bacteria #microbiology #lab
 Quantification: Interbacterial Competition Using Single-Cell Fluorescence Imaging l Protocol Preview
Quantification: Interbacterial Competition Using Single-Cell Fluorescence Imaging l Protocol Preview
 #microbiology #bacteria #youtubeshorts #shortvideo #labs
#microbiology #bacteria #youtubeshorts #shortvideo #labs
Bacterial colonies | culture media | bacterial growth on agar plates | how to grow bacteria #biology
Bacterial colonies | culture media | bacterial growth on agar plates | how to grow bacteria #biology